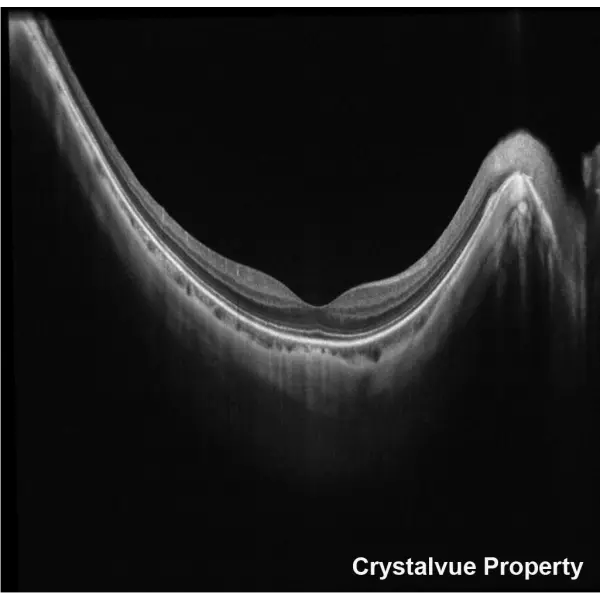
OCT Crystalvue VISION-700 (6).webp
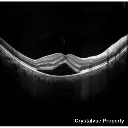
OCT Crystalvue VISION-700 (7).webp

Produits alternatifs
Ces autres produits pourraient vous intéresser
Spécifications
| Marque | Crystalvue |
| Neuf/Occasion | Neuf |
| Etat | Neuf |
| Localisation | France métropolitaine |
| Alignement | Suivi 3D automatique / Mise au point automatique, manuel possible |
| Source lumineuse | OCT : SLED 840 nm / Caméra du fond d’œil : LED blanche (capture) / NIR (alignement) |
| Modes de scan | Mode 3D : Disque optique 3D, Macula 3D, Zone large 3D / Mode ligne : Ligne, Ligne large, Croix 5 lignes, Radial / Mesure de pachymétrie et angle (chambre antérieure) |
| Plage de scan | Mode ligne et 3D : 6 mm x 6 mm (H & V ± 5 %) / Mode ligne large : 12 mm ou moins (± 5 %) |
| Vitesse de balayage | A-scan 80 kHz |
| Résolution en profondeur | < 6 µm |
| Cible de fixation | 15 points internes (vert), 1 point externe ajustable (ambre) |
| Type de revue photographique | Vraie couleur, Red-free, Film négatif |
| Champ de vision en ° | 45° ± 5 % |
| Plage de réglage de la mise au point | -15D à +10D (sans lentille de compensation) / -30D à -10D et +5D à +30D (avec lentille de compensation) |
| Diamètre pupillaire minimum en mm | Ø ≥ 2,5 mm via OCT ; Ø ≥ 3,8 mm via FC |
| Résolution de l’image du fond d’œil | 12 Mégapixels |
| Connectivité | HDMI, USB 3.0, USB 2.0, RJ45/Ethernet |
| Largeur (en mm) | 409 |
| Profondeur (en mm) | 534 |
| Hauteur (en mm) | 546 |
| Poids (en kg) | 32 |
| Disponible à la vente | Oui |